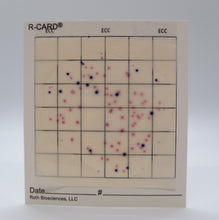
Load image into Gallery viewer, R-CARD® ECC - Pack of 100

Card Size: 3.5"x 4" Capacity: 1mL STORAGE CONDITIONS AND STORAGE LIFE
A revolution in bacteria testing, the R-CARD® test method offers the most convenient, streamlined way to detect not only the presence of E. coli and Coliforms, but also the number of colonies. (NOTE: If the sample contains Aeromonas spp., they may give a similar appearance to the true coliform)
- Completely self-contained, requiring almost no additional equipment
- Extremely accurate and easy to understand results
- Fast results in 15-24 hours (incubated)
- E. coli will show up as dark blue dots, Coliform will show as dark pink/red dots
How It Works
Unlike most E. coli / Coliform media on the market, R-CARD® rapid tests require almost no additional equipment and offer an extremely easy user-experience. Simply lift the R-CARD® ECC clear film and deposit 1 mL of your liquid sample on the card. Then release the clear film so it can fall back on top of the card, covering your sample. Within 1-3 minutes, the liquid sample will solidify between the two layers. This prevents it from dripping or leaking, making R-CARD® rapid tests incredibly easy to transport and use in the field.
For quickest results, it’s best to incubate your sample at 35±0.5°C for 15-24 hours. After the appropriate incubation time, dark blue dots will appear showing E. coli colonies, and dark pink/red colonies will appear showing Coliform colonies. To enumerate, simply count the number of dots for each type.
For more detailed instructions, please check out the PDFs below. Remember, we offer free technical support on any stage of the process and would be happy to instruct and advise you.
Testing 2mL-100mL Aqueous Samples on R-Card® Using Membrane Filter (PDF)
Technical Step-by-Step Instructions: View PDF document
R-CARD General Use Instructions: View PDF document
Additional Helpful and Important Information
Why R-CARD® Rapid Tests Are Better Than Competing Products
R-CARD® rapid tests offer a revolution in convenience without sacrificing accuracy. The cards are completely self-contained and don’t require petri dishes, agar, or other gear that’s fragile and prone to leak. Simply place your sample on the card and wait 1-3 minutes for the liquid sample to solidify between the two layers. This prevents it from dripping or leaking. Cards can easily be stored in a coat or backpack pocket.
It’s also incredibly easy to read the R-CARD’s results. After the appropriate incubation time, simply count the dark blue dots for the number of E. coli colonies and the dark pink/red dots for the number of Coliform colonies. This easy-to-read color system is a significant improvement from other multi-bacteria tests, where differentiating between microbes can be very difficult.
Additional Equipment Needed
While the R-CARD® rapid tests are completely self-contained, you will need a sterile dropper or syringe to dispense your liquid sample onto the card. Once your sample is collected, it’s recommended to use an incubator to rapidly decrease the time it takes to view results (15 to 24 hours with an incubator).
Ideal Uses
- Food & Beverage
- Agriculture
- Environmental Monitoring
- Cosmetics & Personal Care Manufacturing
- Education
- Municipal & Environmental Water
- Pharmaceuticals
- Veterinary
Why Choose Roth Biosciences?
Dr. Jonathan Roth is one of the most well-known names in microbiology and bacteria testing. He was the first to develop testing methods to use enzyme substrates for producing different colors to distinguish different types of bacteria. Roth Biosciences continues to offer some of the most revolutionary innovations in the industry.